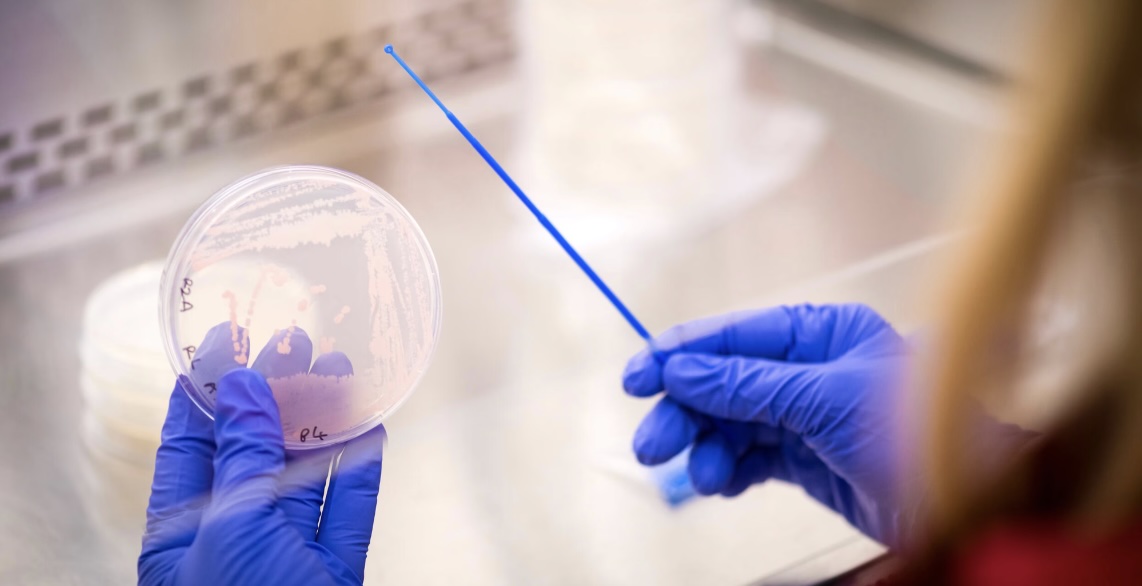

- Home
- Startup news
- BugBiome is decoding nature’s pest control secrets for better crop protection
BugBiome is decoding nature’s pest control secrets for better crop protection
Plant leaves are covered in microbes that have evolved complex mechanisms to protect their hosts from harmful insects. BugBiome is systematically characterizing this natural defence network through video-based behavioral screening, identifying microbes that repel, disrupt, or impair pests while leaving beneficial insects unharmed. They're tapping into millions of years of evolution to discover novel, environmentally compatible crop protection mechanisms.


When Alicia Showering first told Chris Mosedale about her idea to develop mosquito repellents from human skin microbes, he was thoroughly unimpressed. Showering had spent her PhD at the prestigious London School of Hygiene and Tropical Medicine studying why mosquitoes bite some people and ignore others, with the answer lying in the odor profiles influenced by skin microbes. She was deeply committed to the idea of harnessing those protective microbes as a repellent.
Mosedale wasn’t dismissing the science—he saw real potential in using microbes to influence insect behavior. He just thought mosquitoes were the wrong target, and had learned about the complexities of microbiome products in the human context a few years ago in a prior company. The challenge forced Showering to think differently. She recognized that the principles she’d uncovered weren’t specific to mosquitoes and humans at all. “I realized that everything I’d learned about human diseases and mosquitoes was relevant to agricultural pests,” she explains. The core question remained identical: how do microbes influence insect behavior, and could this be harnessed for crop protection?
The pivot to agriculture made the commercial picture clearer. UK and European regulations were changing, leaving farmers with fewer chemical options to protect their crops, and insect resistance was increasing. This regulatory landscape created a significant opportunity for biological alternatives. The idea was intriguing enough that Mosedale, who had sworn off microbiome companies a decade earlier, joined in to co-found BugBiome with Showering.
Letting insects reveal what works
The insight that leaf microbes could protect plants required building an entirely different kind of screening platform. Traditional screens for insect control look for chemicals that kill, but microbes work through subtler mechanisms—altering behavior, reducing feeding, or disrupting reproduction. Standard screening methods miss most of what microbes can actually do.
Working together, they developed a phenotypic screening method using video tracking to analyze normal insect behavior and identify what it means when that behavior changes. The process involves collecting individual microbes from plant surfaces, exposing insects to them, and letting the insects reveal which microbes affect them. If there are patterns in how specific microbes make insects behave, much like with traditional chemical solutions, this can be observed. The goal is to discover entirely novel modes of action, which is critical because novel mechanisms mean insects won’t already be resistant.
Showering: “As Peter [Cauwels, from the biotope team] put it: ‘If you kick the aphids in the kneecaps, they aren’t going to transmit the virus’.”
“If you kick the aphids in the kneecaps, they aren’t going to transmit the virus.”
From discovery to market clarity
After securing initial funding, BugBiome spent its first year on R&D, transitioning from human-focused mosquito work to plants. By early 2025, they were ready to move to development and whole-plant testing. The team recognized a need to bring on investors who understood the agriculture field and could connect them to customers.
Gaining a clear agricultural lens for their company was a key motivator for joining biotope’s Basecamp program, one that would help them see their future trajectory in Europe more clearly. The biotope team and other founders, which included people with experience in the agriculture field, challenged BugBiome on business and technical points and provided a valuable cross-continental perspective on how the European and US markets differ.
Learning from later-stage companies in the biotope portfolio showed them what scaling actually looks like. Companies like Zymofix and Amphistar had invested heavily in their own manufacturing capabilities. “There’s really not a push to manufacture yourselves in the UK. There’s not really government funding to support that,” Showering explains. Seeing how other companies approached manufacturing made them realize this was a strategy they should consider, even though they previously thought it wasn’t an option.
Getting products to farmers
BugBiome sees itself as both a product company and a platform company, but the immediate focus is on finding partners. They are looking for companies with pest targets and portfolio gaps five or ten years in the future which they can apply their discovery engine and microbial bank to solve. Biotope’s network will give them access to potential customers and collaborators they wouldn’t have reached from the UK alone.
“I believe that we can partner with our customers early rather than just continuing alone for the next three years until we have the field trial and regulation data that they want to see for a product,” Showering says.
Partners can bring formulation and field trial expertise to accelerate new insecticides to market faster than BugBiome could alone. Trials are planned in the US and UK this year, with hopes to expand to the EU next year with biotope support.
Showering and Mosedale’s goal for BugBiome is straightforward: multiple insecticides for various insects in field trials, working with partners to take those products through European regulation in the next five to ten years so farmers can actually buy them.

“I’m really fortunate to have a co-founder that’s been there, and has done it before.”
Alicia Showering
Learning to think like a founder
The transition from academic to CEO has required learning new skills like finance and partnership negotiations, but Showering is undaunted, noting, “If you need to do it and you’re in a startup, you work out how to do it and you get on with it”. She credits Mosedale for consistently challenging her to be less academic, adding, “I’m really fortunate to have a co-founder that’s been there, and has done it before”.
Mosedale and Showering will likely keep disagreeing as they scale. “Chris says that I usually disagree with him for three months, before coming round to his point of view,” Showering laughs. “But I’d like to think it’s down to three days now.”
Mosedale hates the company name, by the way. Showering doesn’t mind. Some people ask whether the “bug” in BugBiome refers to the microbes or the insects. “Microbes or insects, I just tell them it can be whatever they want it to be,” she says.
They still haven’t agreed on a new name.
More News
Our 2026 climate tech bets

The fundraising mirage

Typcal is brewing the future of pragmatic protein

AmphiStar secures €12.5m EIC funding

biotope recap: Summer edition

Annick Verween on the VCo2 podcast

2024 wrapped

Networking with cohort six

B’ZEOS celebrates seed round milestone

Tackling food waste at its source

The value of good mentors

Meet our Spring ‘24 cohort

His son’s allergy turned this father into a founder

FlyBlast: on a mission to solve meat

Biosurfactants from food waste? Meet AmphiStar

Probitat interview

B’ZEOS: sustainable packaging made of seaweed

Elogium: Poultry probiotics for safer food

Launch of Biotope ventures fund

Bolder Foods: non-dairy cheese for a better world

BioVox article

Have you got what it takes?
- Pressure-test your biotech with expert feedback
- Align your team and sharpen your strategy
- Turn your startup into an investment-ready business